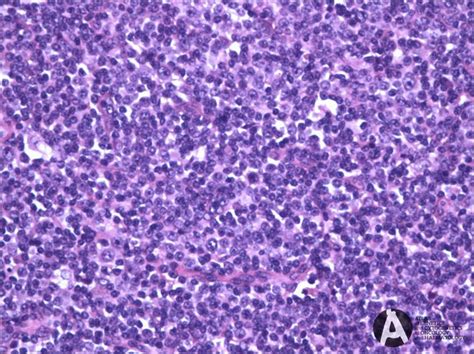

Understanding Nodal Marginal Zone Lymphoma (NMZL)
Understanding Nodal Marginal Zone Lymphoma (NMZL)
Hey guys! Let’s dive into nodal marginal zone lymphoma (NMZL). NMZL is a type of slow-growing non-Hodgkin lymphoma that affects B-cells, which are a type of white blood cell crucial for your immune system. When we say “nodal,” it means this lymphoma primarily hangs out in the lymph nodes. Now, don’t freak out just yet! Understanding what NMZL is, how it’s diagnosed, and what treatment options are available can empower you or your loved ones if you’re facing this diagnosis. We’ll break it down in simple terms and cover everything you need to know.
Table of Contents
What is Nodal Marginal Zone Lymphoma (NMZL)?
Okay, so what exactly is nodal marginal zone lymphoma ? Essentially, it’s a cancer that develops from B-cells, specifically in the marginal zone of the lymph nodes. The marginal zone is a specific area within the lymph node. In NMZL, these B-cells start to multiply uncontrollably and accumulate in the lymph nodes, causing them to swell. Unlike some aggressive lymphomas that spread rapidly, NMZL is generally indolent, meaning it grows slowly. This slower growth often means people might not even realize they have it for quite some time.
To put it simply, imagine your lymph nodes as tiny filtering stations throughout your body. When things like bacteria or viruses enter your system, these lymph nodes activate and help fight off the infection. B-cells are like the soldiers in those stations, producing antibodies to neutralize the threat. In NMZL, these B-cells go rogue; they start replicating without any need and crowd out the healthy cells. While it’s considered a rare type of lymphoma, understanding its characteristics is crucial for effective management and treatment. Knowing that it’s slow-growing provides some reassurance, allowing for careful monitoring and tailored treatment strategies. It is important to distinguish NMZL from other types of lymphomas, especially other marginal zone lymphomas like splenic marginal zone lymphoma (SMZL) and extranodal marginal zone lymphoma of mucosa-associated lymphoid tissue (MALT lymphoma), because treatment approaches and prognoses can vary. The World Health Organization (WHO) classification helps doctors accurately categorize these different lymphomas.
Key Characteristics of NMZL
- Slow-Growing (Indolent): This is a hallmark of NMZL, distinguishing it from more aggressive lymphomas.
- B-Cell Origin: NMZL arises from abnormal B-cells within the marginal zone of the lymph nodes.
- Lymph Node Involvement: Primarily affects the lymph nodes, causing them to enlarge.
- Rarity: NMZL is a relatively uncommon type of lymphoma.
Symptoms and Diagnosis
So, how do you even know if you might have NMZL ? The symptoms can be pretty subtle, which is why it sometimes goes unnoticed for a while. The most common sign is painless swelling of the lymph nodes , usually in the neck, armpit, or groin. You might just feel a lump, but it doesn’t hurt. Other symptoms can include fatigue, night sweats, unexplained fever, and weight loss. These are often referred to as “B symptoms” and can indicate that the lymphoma is more active.
Now, if you’re experiencing any of these symptoms, it’s super important to see a doctor. They’ll start with a physical exam to check for swollen lymph nodes and ask about your medical history. If they suspect lymphoma, they’ll likely order a lymph node biopsy. This involves removing a small piece of the lymph node and examining it under a microscope. This is the gold standard for diagnosing NMZL because it allows pathologists to identify the specific abnormal B-cells. In addition to the biopsy, doctors might order blood tests, such as a complete blood count (CBC) and a comprehensive metabolic panel, to assess your overall health and look for any abnormalities. Imaging tests, like CT scans or PET scans, can help determine the extent of the lymphoma and whether it has spread to other parts of your body. Bone marrow biopsies might also be performed to check if the lymphoma has infiltrated the bone marrow. All these tests together help provide a complete picture of your condition, enabling doctors to stage the lymphoma accurately.
Diagnostic Procedures
- Physical Exam: Checking for swollen lymph nodes.
- Lymph Node Biopsy: Removing a piece of the lymph node for microscopic examination.
- Blood Tests: CBC and comprehensive metabolic panel to assess overall health.
- Imaging Tests: CT scans or PET scans to determine the extent of the lymphoma.
- Bone Marrow Biopsy: Checking for bone marrow involvement.
Treatment Options for NMZL
Alright, let’s talk treatment. The good news is that because NMZL is usually slow-growing, you might not even need immediate treatment. This approach is called “watch and wait” or active surveillance. Your doctor will closely monitor you with regular check-ups and tests, and treatment will only be initiated if the lymphoma starts to progress or cause symptoms. When treatment is necessary, there are several options available, and the best approach depends on the stage of the lymphoma, your overall health, and other individual factors.
One common treatment is rituximab , a monoclonal antibody that targets the CD20 protein found on B-cells. This drug helps to destroy the cancerous B-cells while sparing other cells. Rituximab can be used alone or in combination with chemotherapy drugs. Chemotherapy regimens, such as CHOP (cyclophosphamide, doxorubicin, vincristine, and prednisone) or CVP (cyclophosphamide, vincristine, and prednisone), are often used to treat more advanced cases of NMZL. Another option is radiation therapy, which uses high-energy rays to kill cancer cells. This can be used to target specific areas of the body where the lymphoma is present. In some cases, targeted therapies, such as Bruton’s tyrosine kinase (BTK) inhibitors, may be used, especially if the lymphoma has relapsed or is resistant to other treatments. Splenectomy, or surgical removal of the spleen, may be considered if the lymphoma is primarily affecting the spleen. Stem cell transplantation is another option, although it’s usually reserved for younger patients with relapsed or refractory NMZL. It’s important to discuss all these options with your doctor to determine the most appropriate treatment plan for you.
Treatment Modalities
- Watch and Wait: Active surveillance without immediate treatment.
- Rituximab: Monoclonal antibody therapy targeting CD20.
- Chemotherapy: Regimens like CHOP or CVP to kill cancer cells.
- Radiation Therapy: Using high-energy rays to target lymphoma.
- Targeted Therapies: BTK inhibitors for relapsed or refractory cases.
- Splenectomy: Surgical removal of the spleen.
- Stem Cell Transplantation: Reserved for younger patients with relapsed or refractory NMZL.
Living with NMZL
Dealing with a diagnosis like NMZL can be tough, both physically and emotionally. It’s important to remember that you’re not alone, and there are resources available to help you cope. Support groups can be a great way to connect with other people who are going through similar experiences. Sharing your feelings and hearing from others can provide a sense of community and reduce feelings of isolation. Maintaining a healthy lifestyle, including a balanced diet and regular exercise, can help improve your overall well-being and boost your immune system. Managing stress through relaxation techniques, such as meditation or yoga, can also be beneficial. Open communication with your healthcare team is essential. Make sure to ask questions and voice any concerns you may have. They can provide you with the information and support you need to make informed decisions about your treatment and care. Remember, everyone’s journey with NMZL is unique, and it’s important to focus on taking care of yourself and finding what works best for you.
Tips for Managing NMZL
- Join Support Groups: Connect with others facing similar challenges.
- Maintain a Healthy Lifestyle: Balanced diet and regular exercise.
- Manage Stress: Use relaxation techniques like meditation or yoga.
- Communicate with Your Healthcare Team: Ask questions and voice concerns.
- Seek Emotional Support: Talk to friends, family, or a therapist.
Recent Advances and Research
Okay, so what’s new in the world of NMZL research? Researchers are constantly working to better understand this lymphoma and develop more effective treatments. Recent studies have focused on identifying specific genetic mutations that may contribute to the development of NMZL. Understanding these mutations could lead to the development of targeted therapies that specifically target these abnormalities. There’s also ongoing research exploring the role of the immune system in NMZL and investigating new immunotherapies that can help boost the body’s natural defenses against the lymphoma. Clinical trials are essential for evaluating new treatments and improving outcomes for patients with NMZL. If you’re interested in participating in a clinical trial, talk to your doctor to see if there are any trials that might be a good fit for you. Staying informed about the latest advances in NMZL research can empower you to make informed decisions about your care and treatment.
Areas of Ongoing Research
- Genetic Mutations: Identifying specific mutations that contribute to NMZL.
- Immunotherapy: Exploring new ways to boost the immune system’s response.
- Targeted Therapies: Developing drugs that specifically target abnormal cells.
- Clinical Trials: Evaluating new treatments and improving outcomes.
Conclusion
So, there you have it! We’ve covered a lot about nodal marginal zone lymphoma (NMZL) . Remember, while it can be a challenging diagnosis, understanding the disease, its symptoms, and the available treatment options is the first step towards managing it effectively. With a slow-growing nature, NMZL often allows for a proactive approach, where monitoring and timely intervention can significantly impact the quality of life. Early detection through awareness of symptoms like painless lymph node swelling, combined with accurate diagnosis via biopsy and imaging, sets the stage for tailored treatment strategies. The continuous advancements in research, from identifying genetic mutations to exploring novel immunotherapies, offer hope for improved outcomes. Whether it’s through active surveillance, targeted therapies, or participation in clinical trials, the path to managing NMZL is paved with informed decisions and a strong partnership with your healthcare team. Staying connected with support groups and prioritizing a healthy lifestyle can further empower you to navigate this journey with resilience and optimism. Don’t hesitate to reach out to your healthcare providers for any questions or concerns, and remember, you’re not alone in this! Stay informed, stay proactive, and stay positive!